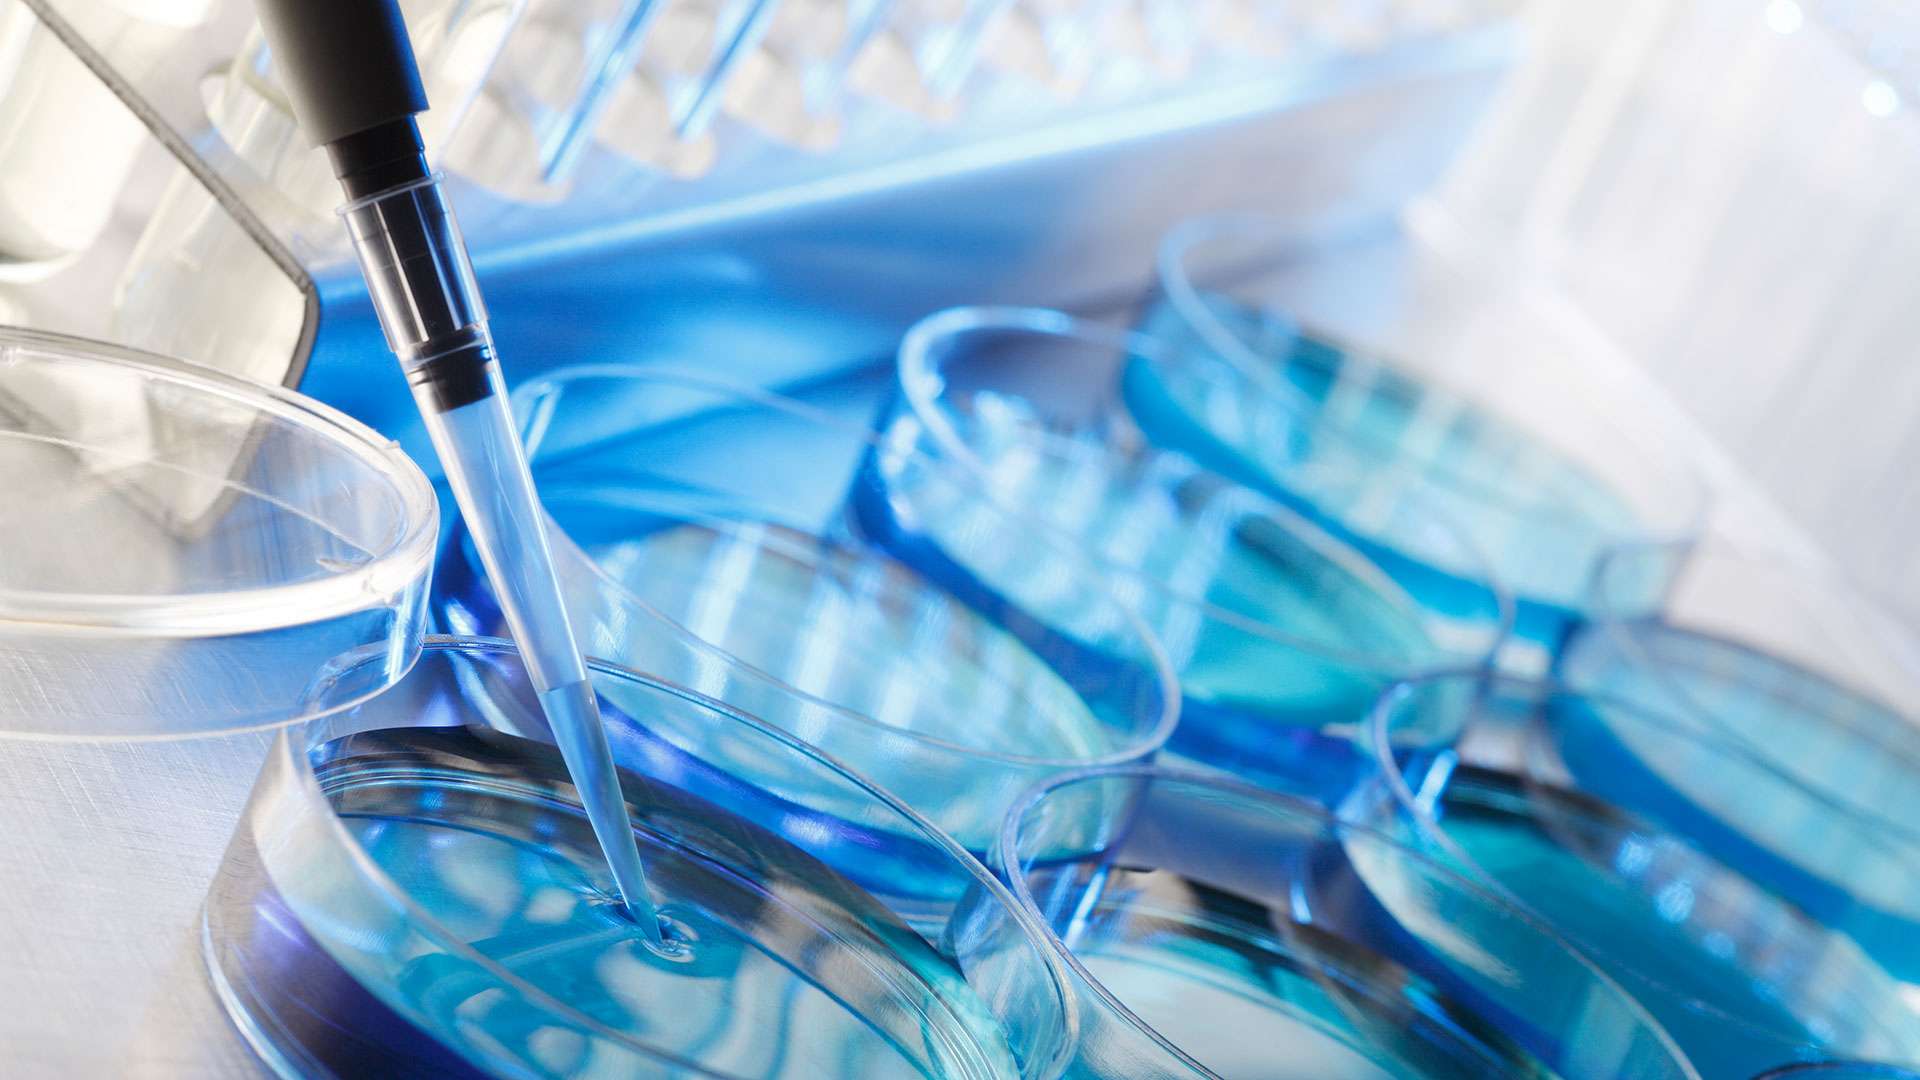
El diagnóstico molecular sobre el tumor o mediante el estudio de la sangre del paciente, permite personalizar el tratamiento según el perfil único de la persona y su enfermedad (Getty)

El ADN o ácido desoxirribonucleico es nuestra huella genética única, es el responsable de que seamos lo que somos. Por eso, conocer la estructura molecular del ADN revolucionó la ciencia, al permitir comprender cómo se transmite la información genética.
Descifrar el genoma humano abrió la puerta a nuevos senderos de investigación científica y, además, acceder a la información del material genético mejoró el escenario para el tratamiento de enfermedades como el cáncer, ya que permite individualizar los tratamientos adaptándolos a cada paciente.
Gracias a estos avances, gradualmente, se empieza a definir a las patologías oncológicas por sus características moleculares. y en menor medida, por su localización en los órganos y tejidos.
En las terapias contra el cáncer, “los avances en el conocimiento del ADN se aplican principalmente de dos formas: en primer lugar, en el diagnóstico de los tumores y los biomarcadores moleculares para entender por qué se originó el cáncer, si es que existe alguna alteración específica que haya causado ese cáncer”, explicó a Infobae el doctor Gonzalo Recondo, jefe de Oncología Clínica del Instituto Universitario CEMIC.
“En segundo lugar, la información genética se aplica para el desarrollo de terapias nuevas que son tratamientos dirigidos contra los tumores que tiene alguna particularidad, o una mutación puntual o una alteración específica del ADNque lo hace susceptible a tratamientos dirigidos”, amplió el experto.
Cada célula humana contiene toda la información genética dentro del ADN. Esa información se almacena a través de un código compuesto por cuatro bases químicas –adenina (A), guanina (G), citosina (C) y timina (T)–, que se emparejan entre sí formando pares de bases. El código genético a su vez, se traduce en la producción de proteínas que son las responsables de desempeñar distintas funciones en los organismos. Si un gen sufre cambios, también pueden cambiar las proteínas y, en consecuencia, las funciones que desempeñan, dando lugar en algunos casos al desarrollo y la progresión de enfermedades.
Es importante destacar que no todas las enfermedades se desarrollan porque exista una alteración genética, pero existen muchas afecciones en las que se logró identificar alteraciones genéticas que predisponen a su desarrollo.
“Conocer las alteraciones que ocurren en el ADN y que causan algunas enfermedades es relevante para poder diagnosticarlas y tratar a las personas de manera acorde. Esto es así para diferentes enfermedades como algunos tipos de tumores sólidos, tumores hematológicos y enfermedades genéticas hereditarias”, señaló el doctor Recondo.
Hace un tiempo atrás, se consideraba a los factores ambientales y genéticos como responsables del desarrollo de las enfermedades, pero actualmente se sabe, en el caso del cáncer, que esos factores ambientales pueden causar alteraciones en el ADN más allá de las que heredamos de nuestros padres.
Más de 300 genes están relacionados con el desarrollo y la progresión del cáncer y existe la tecnología diagnóstica disponible para poder estudiarlos en los tumores de los pacientes. Cada persona es única y su enfermedad también, por eso conocer las alteraciones genéticas particulares de los tumores permite al médico oncólogo elaborar planes de tratamiento personalizados y precisos.

Contemplar al paciente desde una visión integral y no únicamente como portador de una enfermedad es la clave para los tratamientos individualizados.
El jefe de Oncología del Instituto Universitario del CEMIC dijo a Infobae que “el tratamiento oncológico se personaliza con un abordaje integral del paciente, teniendo en cuenta los factores clínicos, pero también los socioeconómicos, culturales y espirituales. Entonces, al momento del diagnóstico y el tratamiento, se busca hacer más preciso este diagnóstico para poder darle a cada persona el mejor tratamiento de acuerdo al subtipo molecular del tumor, a las características de los biomarcadores que tiene ese tumor, al lugar donde está localizado y a las características clínicas del paciente”.
Este tipo de tratamientos dirigidos a alteraciones genómicas aporta un gran beneficio a los pacientes: reduce considerablemente los efectos secundarios de las terapias para combatir los tumores. Al conocer las alteraciones que pueden estar presentes en los tumores (biomarcadores), se puede identificar qué pacientes pueden recibir un tratamiento específico. El resultado es un tratamiento más efectivo pero también menos tóxico.
“Los tratamientos basados en el perfil genético tienen menos efectos adversos porque las drogas se diseñan para ir a atacar puntualmente una proteína del tumor, que es una proteína mutada, que habitualmente no está expresada en otras células normales. Estas drogas están dirigidas a la enfermedad oncológica y tienen menos efectos adversos en el resto de las células en comparación, por ejemplo, con la quimioterapia que ataca las células cancerígenas pero también tiene un efecto de deterioro sobre las células normales”, explicó Recondo a Infobae.

“Realizar un diagnóstico molecular sobre el tumor o mediante el estudio de la sangre del paciente, entre otros biomarcadores, permite personalizar el tratamiento según el perfil único de la persona y su enfermedad, a través de la selección de tratamientos dirigidos, aprobados o en desarrollo”, agregó el experto del CEMIC.
“Completar el mapa genético con el proyecto genoma humano permitió a la medicina personalizada, y en particular a la medicina de precisión, enfocarse en el desarrollo de terapias dirigidas a alteraciones genómicas. Este conocimiento junto con el desarrollo de tecnologías diagnósticas como la secuenciación genómica de segunda generación, introdujeron un cambio de paradigma pasando de las terapias sistémicas “para todos” a terapias dirigidas e inmunoterapias como parte de un plan de tratamiento personalizado”, explicó Verónica Sotomayor, líder del equipo de medicina personalizada de Roche Farma Argentina.
Además de las ventajas para los pacientes vinculadas a los tratamientos personalizados, estas terapias también disminuyen la tensión sobre los sistemas de salud, ya que evitan terapias innecesarias y sus efectos secundarios, optimizando los recursos.
“Para el sistema de salud la medicina personalizada permite optimizar la inversión en recursos económicos en el cuidado de las personas, ya que al proveer una medicación dirigida y seleccionada en base a estudios genéticos y otros, el tratamiento tiene mayor impacto en tasas de curación o control en algunos tipos de enfermedad”,concluyó Recondo.
SEGUIR LEYENDO:
El ADN y la genética en 6 hitos: cómo la ciencia cambió el presente y el futuro de la humanidad
Crean una prueba de ADN capaz de detectar a la vez más de 50 enfermedades de difícil diagnóstico
¿Puede un test genético predecir el riesgo que tiene una persona de enfermar gravemente de COVID-19?
Source El ADN del cáncer: el perfil genético del paciente permite personalizar el tratamiento